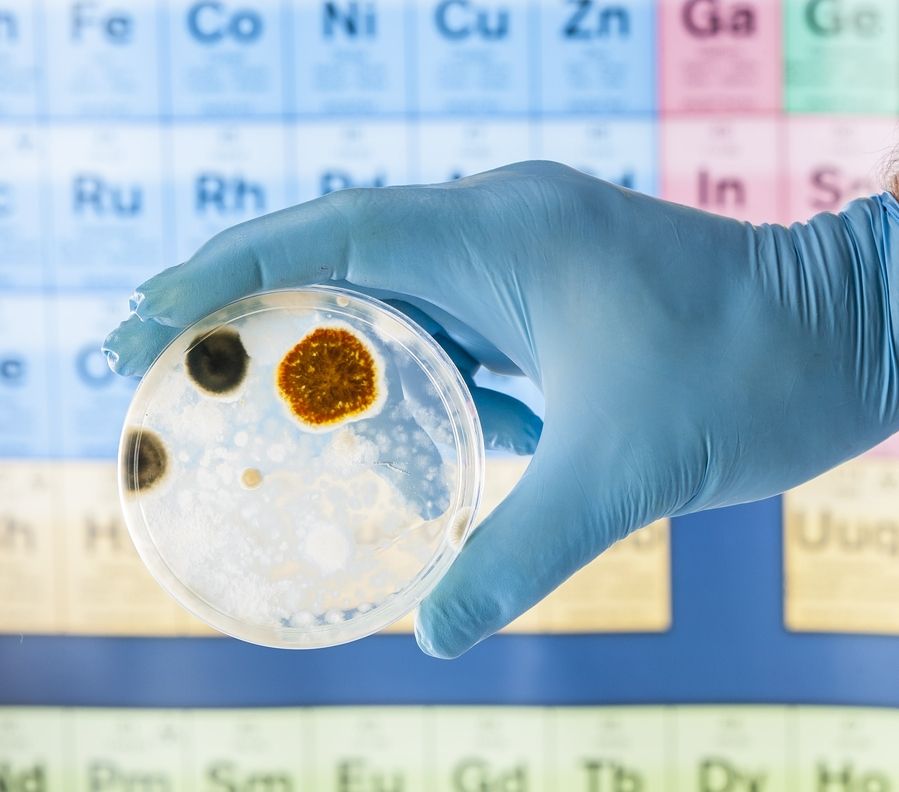
Eine Person mit Handschuhen hält eine Petrischale mit Schimmelpilz darauf.
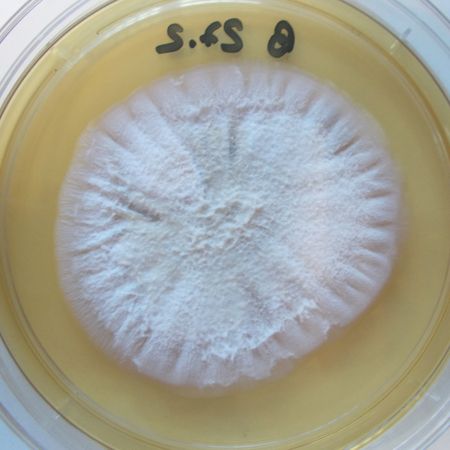
Detailaufnahme von Sarocladium kiliense
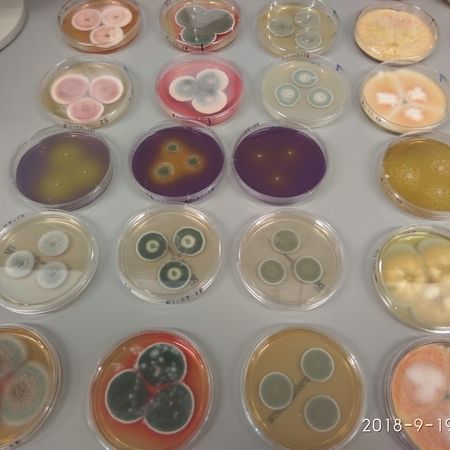
verschiedene_Talaromyces_species-min

Mikroskopische Schimmelpilzanalysen in Eberswalde
Sind Ihre Räume von Schimmel betroffen? Mit einer mikroskopischen Schimmelpilzanalyse finden wir es heraus.
Schimmelpilze in Innenräumen sind nicht nur ein optischer Makel, sondern kann zu gesundheitlichen Problemen führen. Mit dem Angebot der LWU Lebensmittel-, Wasser-und Umwelthygiene GmbH sind Sie in puncto Schimmel auf der sicheren Seite: Wir können Schimmelpilze an verdächtigen Stellen auf Tapeten oder anderen Materialien auf Gattungsebene nachweisen.
So kommt es zu Schimmel im Raum
In der Natur erfüllen Schimmelpilz die ökologisch wichtige Aufgabe, organisches totes Material abzubauen und die Bestandteile in den natürlichen Kreislauf zurückzuführen. Die Pilzsporen, mit denen sich die Schimmelpilze vermehren, werden unter anderem über die Luft verbreitet und kommen folglich überall, auch in der Wohnung, vor.
Wenn Schimmelpilze in Innenräumen wachsen, zeigt sich dieses Wachstum durch eine zu hohe Luftfeuchtigkeit. Die Ursachen für das Auftreten von Feuchtigkeit sind:
Ohne eine schnelle Trockenlegung bleibt die Nässe über längere Zeit im Gemäuer bestehen. Sie bildet die Grundlage für das Auskeimen von Pilzsporen, es entstehen die typischen Schadensbilder.
Die zweite Ursache ist die Luftfeuchte im Raum und in kalten Bereichen von Wänden. Wenn die Luftfeuchte ausreichend hoch ist und hinreichend kalte Wandbereiche (sogenannte Kältebrücken) vorliegen, schlägt sich die Feuchtigkeit dort als Kondens- oder Tauwasser nieder. In diesem Fall ist ausreichend Wasser für das Wachstum von Schimmelpilzen gegeben. Der Zusammenhang der verschiedenen Faktoren ist oft kompliziert und nicht unbedingt sofort zu erkennen. Daher bedarf jede Analyse von Schimmelpilzwachstum in Wohnräumen einer genauen und individuellen Untersuchung.

Diese gesundheitlichen Probleme können auf Schimmel zurückzuführen sein
Schimmelpilze können verschiedene körperliche Beschwerden, zum Beispiel Atemwegserkrankungen, Hautausschläge oder Kopfschmerzen, verursachen, da einige Arten Pilzgifte bilden. Das in den Pilzen oder deren Sporen eingelagerte Gift gelangt durch Atmung oder Berührung in den Körper. Auch sind allergische Reaktionen möglich. Jeder Mensch reagiert individuell auf Schimmelpilze.
Unsere Leistungen gehen über die Schimmelpilzanalyse hinaus. Gerne übernehmen wir außerdem die Analytik von Wasser und Lebensmitteln oder die Hygienekontrolle in Krankenhäusern.